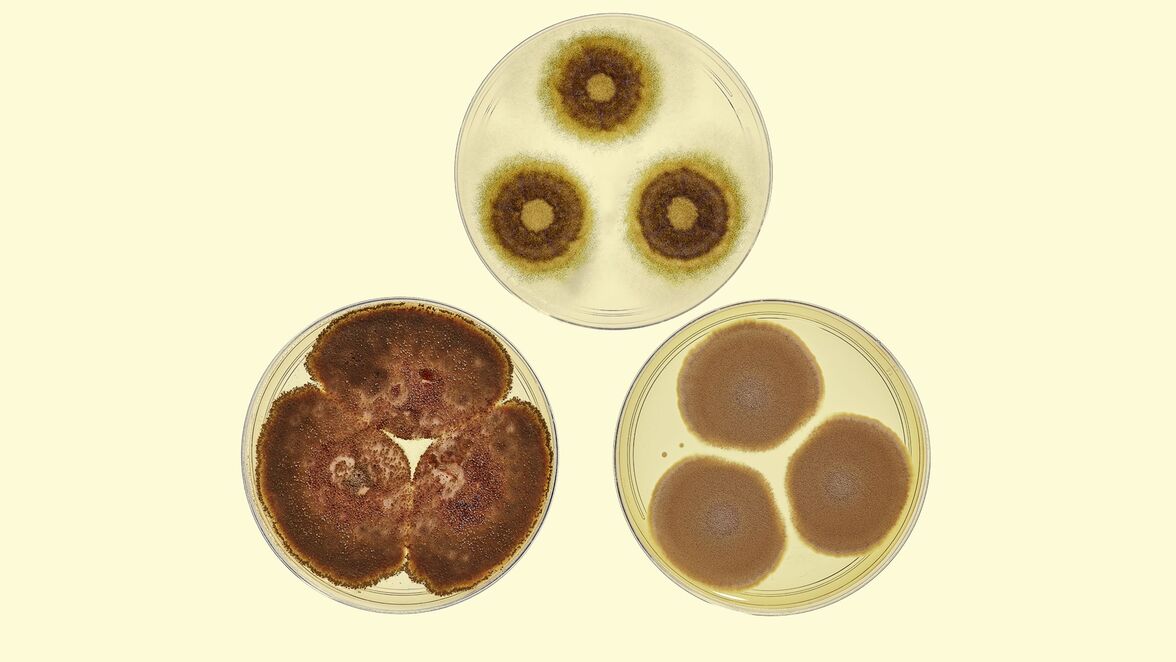
Исследователи сообщают о росте числа грибковых инфекций с лекарственной резистентностью в мире

Рост резистентности к противогрибковым препаратам усугубляет бремя инвазивных грибковых инфекций, а также потенциально способствует увеличению числа резистентных дерматомикозов.
Рост заболеваемости инвазивными и кожными грибковыми инфекциями происходит параллельно с развитием медицинских вмешательств, таких как иммуносупрессивные препараты для лечения рака и снижения отторжения органов после трансплантации. Эпидемиологические данные, опубликованные в журнале Microbial Cell, свидетельствуют о том, что рост тяжелых грибковых инфекций ежегодно приводит к более чем 150 миллионам случаев заболевания и почти 1,7 миллиона смертельных исходов во всем мире.
В недавнем исследовании, опубликованном в журнале Pathogens and Immunity, Томас Маккормик и Махмуд Ганнум, профессора дерматологии Медицинской школы Западного резервного университета США, объясняют, как растущая резистентность к противогрибковым препаратам усугубляет проблему инвазивных грибковых инфекций. "Это не просто проблема, которая затрагивает отдельных пациентов", - говорит Маккормик. "ВОЗ признала ее широкомасштабной угрозой, которая может повлиять на целые системы здравоохранения, если не принять меры". Основываясь на данных, исследователи сформулировали меры предосторожности и "призыв к действию" для медицинского сообщества. "Медицинские работники должны уделять первоочередное внимание диагностическим тестам, когда сталкиваются с неизвестной грибковой инфекцией", - отметил Ганнум. "Раннее выявление может иметь огромное значение для улучшения состояния пациентов".
Относительно новой тревожной тенденцией в области противогрибковой резистентности является появление нескольких видов грибков, которые в настоящее время демонстрируют множественную лекарственную резистентность (например, Candida auris, Trichophyton indotineae). Повышение осведомленности об этих видах с множественной лекарственной резистентностью имеет первостепенное значение. В исследовании, недавно опубликованном в журнале Emerging Infectious Diseases, исследовательская группа Ганнума и сотрудники Центра по контролю и профилактике заболеваний (CDC) США подробно описали случай, продемонстрировавший, что Trichophyton indotineae не только приобретает лекарственную резистентность, но и передается половым путем.
Для решения растущей проблемы здравоохранения авторы предлагают несколько мер:
- Повышение осведомленности и уровня образования: повышение осведомленности в системе общего здравоохранения, что позволит получить более точное представление о росте числа инфекций, резистентных к противогрибковым препаратам. Для повышения осведомленности населения в сфере здравоохранения необходимо расширить просветительскую работу в отношении потенциальных грибковых инфекций, что может привести к более реалистичному представлению о распространенности инфекций, резистентных к противогрибковым препаратам.
- Диагностические тесты: более широкое использование диагностических тестов (например, микро- и макроскопических традиционных анализов или молекулярного тестирования) должно стать рутинной практикой для медицинских работников, столкнувшихся с неизвестной грибковой инфекцией.
- Тестирование на чувствительность к противогрибковым препаратам: увеличение числа квалифицированных лабораторий, способных проводить эти тесты.
Призыв к действию: решение возникающей проблемы резистентности к противогрибковым препаратам требует согласованных усилий медицинских работников, исследователей, политиков и фармацевтической промышленности по разработке и внедрению стратегий по управлению и профилактике резистентности к противогрибковым препаратам. "Конечная цель этих мер, - говорит Ганнум, - заключается в повышении качества обслуживания пациентов путем обеспечения эффективного лечения и предотвращения дальнейшей эскалации проблемы".